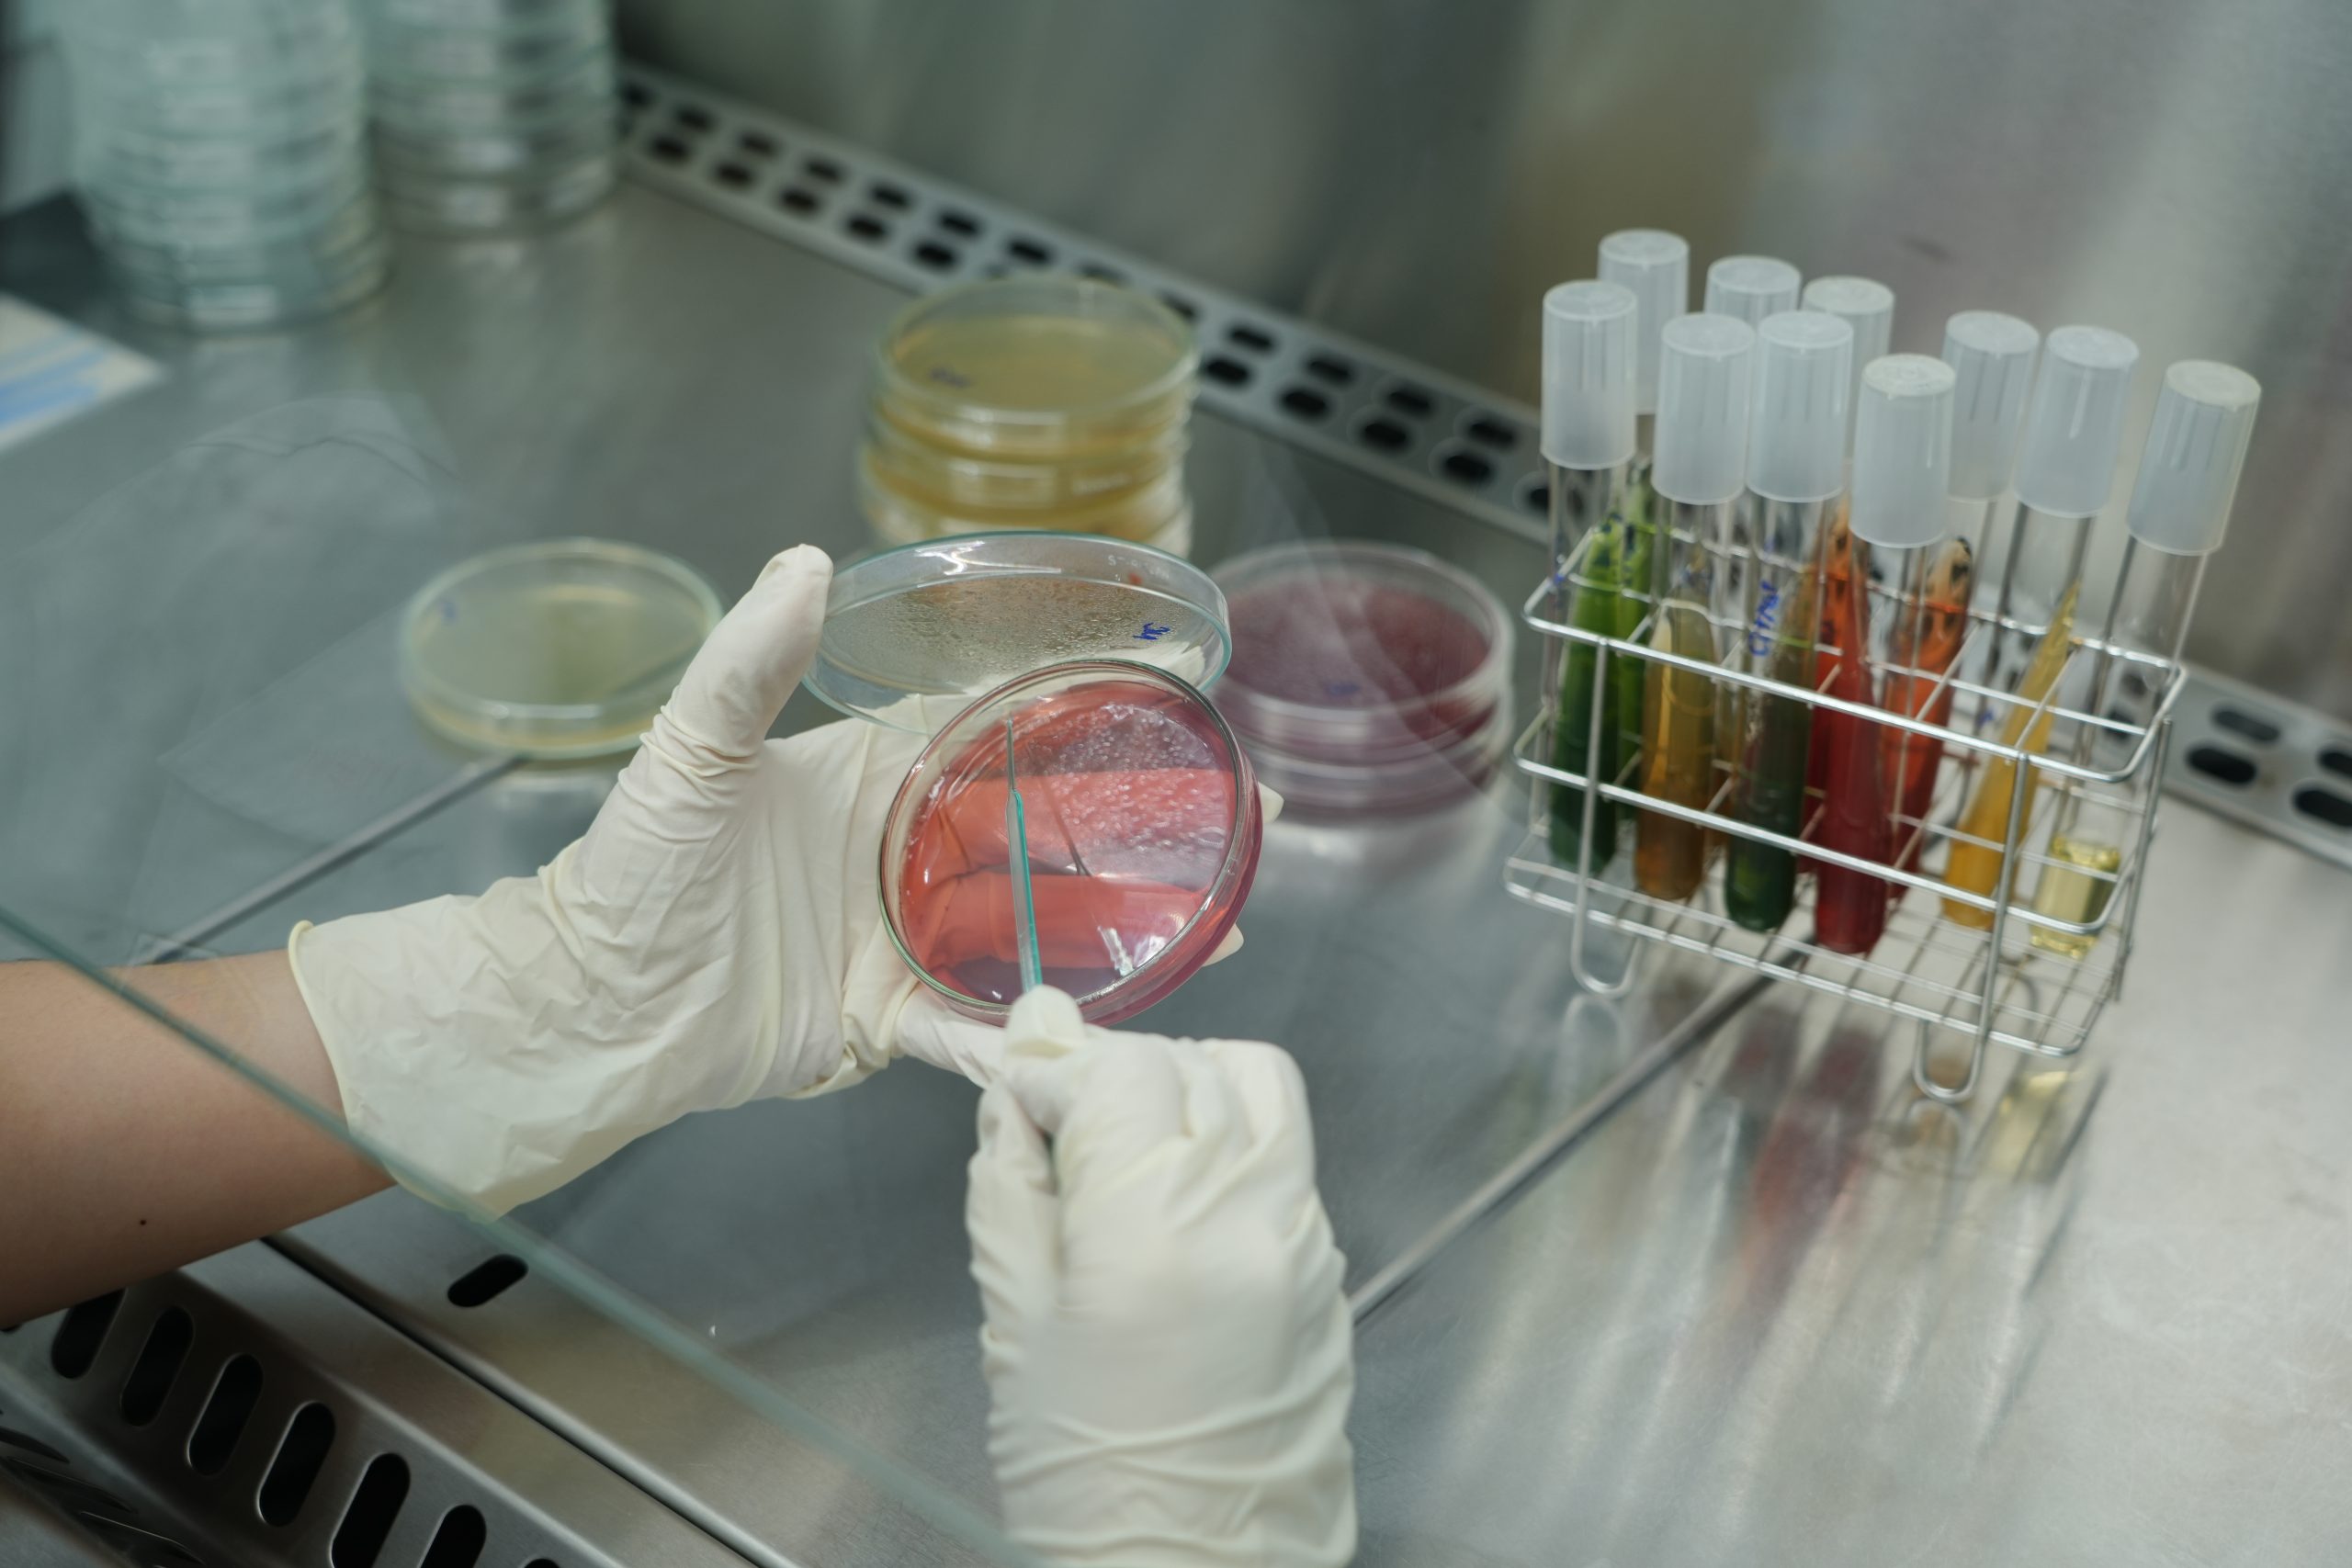

Nhằm tạo điều kiện cho các cử nhân Xét nghiệm Y học nâng cao trình độ chuyên môn và đáp ứng điều kiện hành nghề theo quy định, Trường Đại học Nguyễn Tất Thành thông báo tuyển sinh hệ Chuyên khoa cấp I sau đại học năm 2025 với thông tin như sau:
THÔNG TIN TUYỂN SINH
– Ngành đào tạo: Kỹ thuật Xét nghiệm Y học
– Đối tượng: Người học đã tốt nghiệp đại học ngành Xét nghiệm Y học và có chứng chỉ hành nghề phù hợp
– Hình thức đào tạo: Trực tiếp & Trực tuyến
HỒ SƠ DỰ TUYỂN BAO GỒM
- Phiếu đăng ký dự thi Chuyên khoa cấp I
- Sơ yếu lý lịch (có xác nhận của cơ quan/chính quyền địa phương)
- Xác nhận thâm niên công tác chuyên ngành (nếu có)
- Công văn cử đi học của đơn vị (nếu có)
- Bản sao có chứng thực:
– Bằng tốt nghiệp và bảng điểm đại học
– Chứng chỉ hành nghề
– Căn cước công dân
– Giấy tờ ưu tiên (nếu có)
– Giấy khám sức khỏe (trong vòng 06 tháng) - 04 ảnh 3×4 (ghi rõ họ tên, ngày tháng năm sinh ở mặt sau)
- 01 phong bì có dán tem và ghi rõ địa chỉ liên hệ
Chi tiết vui lòng xem tại: https://bit.ly/TBtuyensinhCKI-NTTUnam2025
LIÊN HỆ NỘP HỒ SƠ
Phòng Liên kết Đào tạo – Trường Đại học Nguyễn Tất Thành
– Địa chỉ: 298A Nguyễn Tất Thành, Phường 13, Quận 4, TP. Hồ Chí Minh
– Tổng đài: 1900 2039 (nhánh 336)
– Hotline:
– Cô Thảo Nguyên – 0986 155 044
– Thầy Văn Đức – 0974 926 690
Khoa Kỹ thuật Xét nghiệm Y học kính mời quý anh/chị cử nhân ngành Kỹ thuật Xét nghiệm Y học quan tâm đăng ký dự tuyển đúng thời gian quy định. Đây là cơ hội để phát triển chuyên môn, chuẩn hóa chứng chỉ hành nghề và hướng đến sự nghiệp bền vững trong lĩnh vực Kỹ thuật Y học.

Huỳnh Trần Phương Luân – K.KTXNYH
 1900 2039
1900 2039






